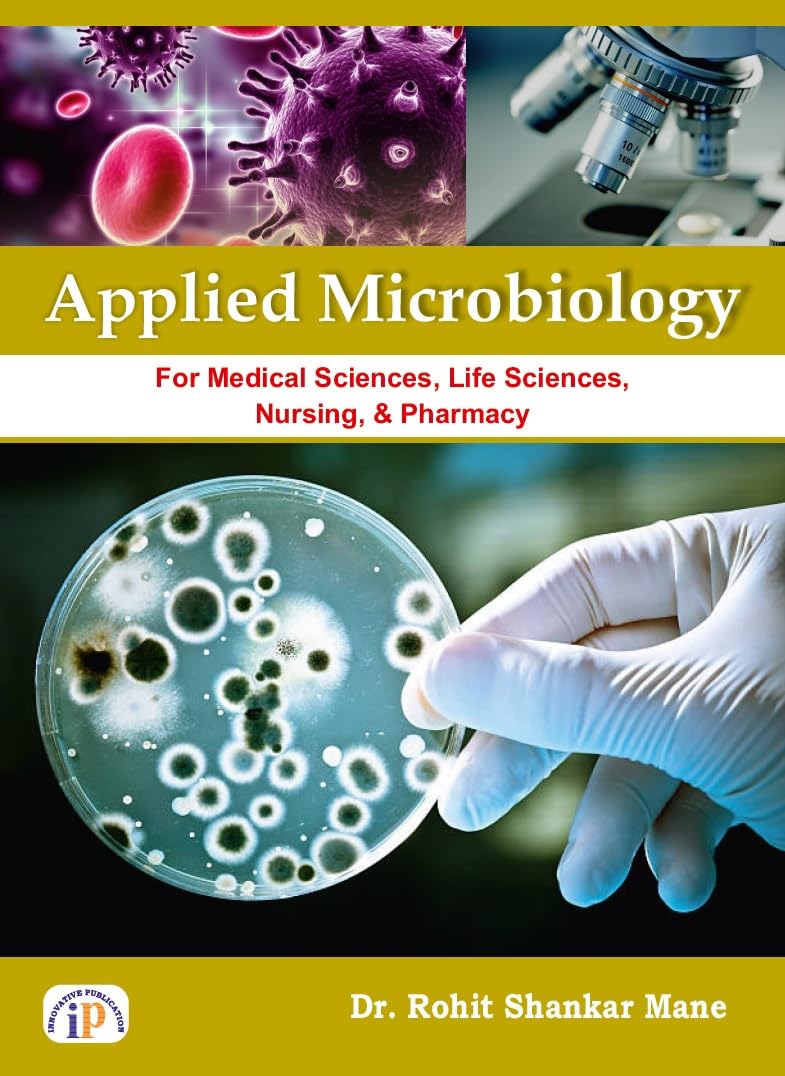

-
Home
-
Subjects
- Administration & Management
- Allergy & Infectious Diseases
- Anaesthesia
- Anatomy
- Anatomy and Physiology
- Assessment & Diagnosis
- Basic Science
- Behavioral Science
- Biochemistry
- Biochemistry For Nurses
- Biomedical science
- Biophysics
- Biostatistics
- Cardiology
- Care Planning
- Cell Biology
- Communication and Educational Technology
- Community Dentistry
- Community Health Nursing
- Community Medicine
- Complementary Medicine
- Conservative Dentistry
- Critical Care
- Crown and Bridge
- Cytology
- Dental Materials
- Dermatology / Skin
- Diabities
- Dictionary
- Dietetics
- Embryology
- Emergency Medicine
- Endocrinology
- Endodontics
- Epidemiology
- First Aid
- Forensic Medicine and Toxicology
- Forensic Nursing
- Fundamentals and Foundations of Nursing
- Gastroenterology
- General English
- Genetrics
- Geriatric & Family Medicine
- Gerontology
- Gynaecology
- Haematology
- Hepatology
- Histology
- Hospital Management / Medical Education
- Immunology
- Infectious Disease
- Instruments
- Internship
- Leprosy
- Medical Laboratory Technology
- Medical Statistics
- Medical Surgical Nursing
- Medicine
- Microbiology
- Midwifery
- Molecular Biology
- MRCP/MRCS/MFDS
- NCLEX
- Nephrology
- Neuroanatomy
- Neurology & Neurosurgery
- Nurse Assisting
- Nursing Education
- Nursing Informatics and Technology
- Nursing Management & Services
- Nursing Management and Leadership
- Nursing Research and Statistics
- Nutrition
- Obstetrics
- Oncology
- Ophthalmology
- Oral And Maxillofacial Surgery
- Oral Histology
- Oral Medicine And Radiology
- Oral Microbiology
- Oral Pathology
- Orthodontics
- Orthopaedics
- Osteology
- Others
- Otolaryngology (ENT)
- Paediatric & Preventive Dentistry
- Pain Medicine
- Palliative Medicine
- Parasitology
- Pathology
- Pathology & Genetics
- Pediatric Nursing
- Pediatrics
- Periodontology
- PGDEE
- PGMEE
- Pharmacology
- Physical Medicine &,Rehabilitation
- Physiology
- PLAB
- Plastic Surgery
- Preventive and Social Medicine
- Prosthodontics
- Psychiatric and Mental Health Nursing
- Psychiatry
- Psychology
- Public Health Dentistry
- Pulmonary Medicine / Respiratory Medicine
- Radiology
- Rheumatology
- Sleep Medicine
- Sociology
- Sports Medicine
- Staff Nurse Entrance / Nursing Competition Exams
- Super Speciality
- Surgery
- Therapeutics
- Tumours
- UG Exam Books / MCQs / Viva
- Urology
- USMLE
- Vascular Surgery
- Physiotherapy
- Pharmacy
- Homeopathy
- Implantology
- FMGE
- Ayurveda
- General Practice/Physician
- Veterinary
- A.N.M- Auxiliary Nursing Midwifery
- G.N.M-General Nursing and Midwifery
- GMAT/GRE
- NEET UG PREP
- Orthopedics
- Hematology
- Obstetrics & Gynecology
- Internal Medicine
- Adult Health (Medical Surgical) Nursing
- Oral Maxillofacial Surgery
- Clinical Lab Sciences
- Anesthesia
- Chiropractic
- Physical Therapy
- Conservative Dentistry & Endodontics
- General Anatomy, Embryology & Histology
- Urology
- Oral Medicine & Radiology
- Health Education And Wellness Series
- General Surgery
- Hospital Administration
- Community, Preventive & Social Medicine
- Community, Preventive & Social Medicine
- Community, Preventive & Social Medicine/Nursing Research & Statistics
- Otolaryngology/Smart Study Series
- General Pathology & Microbiology
- General Medicine
- Child Health Nursing
- Midwifery / Obstetrics & Gynecology (OBG) Nursing
- Nursing Management & Leadership
- Orthopedics/ Internal Medicine
- Chaitow
- Cam & Massage
- Neurology
- Medicine
- Medicine
- Medical Teaching
- Competitive Examination
- Applied Psychology
- Anatomy & Physiology
- Oral Pathology & Oral Microbiology
- Radiology/ Imaging technology
- Professionalism, values & Bioethics
- Pediatrics
- Nursing Foundation
- Ophthalmology/ Optometry
- Clinical Lab Sciences
- Respiratory Care
- Pathology
- Internal Medicine, Pediatrics
- Oral Anatomy, Embryology & Histology
- Medical Science
- Cardiology / Nuclear Medicine
- Head and Neck Surgery
- Surgery / Cartilage Repair
- Orthopedic Trauma / Medicolegal Reporting
- Hematology / Stem Cell Transplantation
- Pediatric Palliative Care
- Emergency Medicine / Radiology
- Optics / Optical Science
- Oncology / Hematopathology
- Cardiothoracic Surgery
- Hand Surgery / Orthopedics
- Orthopedics / Sports Medicine
- Orthopedics / Sports Medicine
- Emergency Medicine / Orthopedics
- Internal Medicine
- Information Technology {IT}
-
Booktype
-
MBBS
-
BDS
-
Nursing
-
Exclusive
-
Oxford Medi. Handbooks
-
WHO Series
-
Ayurveda
-
General Books
- Art/Architecture/History
- Astrology
- Autobiographies And Biographies
- Automobile Engineering
- Biography/Leadership
- Bioinformatics
- Biotechnology
- Business
- Career
- Change Management
- Children?s Books
- Civil Engineering
- Communication
- Communication/Reference
- Banking Computer Science
- Cookery
- Corporate Governance
- Creativity
- Current Affairss
- Economics
- Electronic Commerce
- Engineering Mathematics
- Entrepreneurship
- Environmental Management
- Environmental Technology & Management
- Ethics
- Family Businesse
- Fiction
- Finance
- Games & Puzzles
- General Management
- General Reference
- Health/Memoiru
- History
- Hospitality & Tourism
- Human Resource Management
- Humour
- International Business
- Karma & Reincarnation
- Law
- Library Science
- Management Control Systems
- Management Information Systems
- Management Skillsn
- Marketing
- Mass Media
- Mechanical Engineering
- Meditation/Spirituality
- Mind, Body & Spiritri
- Motivation/Self-Help
- Nanotechnology
- Numerology
- Occult/Spirituality
- Outsourcing & Offshoring
- Palmistryr
- Parapsychology
- Parenting
- Personality Development
- Philosophy/Biography
- Poetry
- Political Science
- Popular Science
- PR & Advertising
- Pregnancy & Baby Care
- Production & Operations Management
- Production Engineering
- Project Management
- Quality Management
- Quotes On Management
- Reference
- Economic Relationships
- Religion
- Risk Management
- Sales
- Science
- Self-Help
- Sex, Marriage & Love
- Short Fiction
- Social/Political Science
- Sport/Biography
- Sports
- Strategy
- Supply Chain Management
- Test Prepb
- Time Management
- Travel
- All Others
-
Elsevier 1st Year Titles
Applied Microbiology for Medical Sciences, Life Sciences, Nursing and Pharmacy
Shipping Fee Included
| ISBN | 9788196276263 |
| Published Year | 2023 |
| Publisher | IP Innovative Publication |
| Condition | New |
| Language | English |
| Edition | 1st |
| Binding | Paperback |
| Return Availability | Returnable upto 3days (*T&C applied) |
Get Additional 2% OFF, use PROMOTEAIBH2
Pay On
Delivery
Quick Dispatch
(Within 2 Day)
3 Days
Returnable
Enter pincode to check COD availability
Share Product
Specification
General
FAQ
-
What is AIBH?
All India Book House (AIBH) is one famous Retailer, Wholesaler, Importer and Supplier of Medical Books. With Head Office in Nai Sarak (near Chandni Chowk-Delhi) that is lined with many bookshops and thronged by book lovers from across the world.
-
How AIBH offers best price for medical books?
AIBH is exlucsive partners with multiple publishers resulting which we get the best prices which we pass on to our consumers directly without any third party involvement.
-
What is estimated delivery time?
Delhi NCR - 1-3 Days
North India/Metro City - 4-6 Days
Rest of India/Special Zone : 5-7 Days
Due to Covid-19 products ships in 1-2 days -
Do you take returns?
Yes we take returns, to read more about our return policy click here https://www.aibh.in/return-policy
-
Do you offer COD/Cash On Delivery?
Yes we offer COD